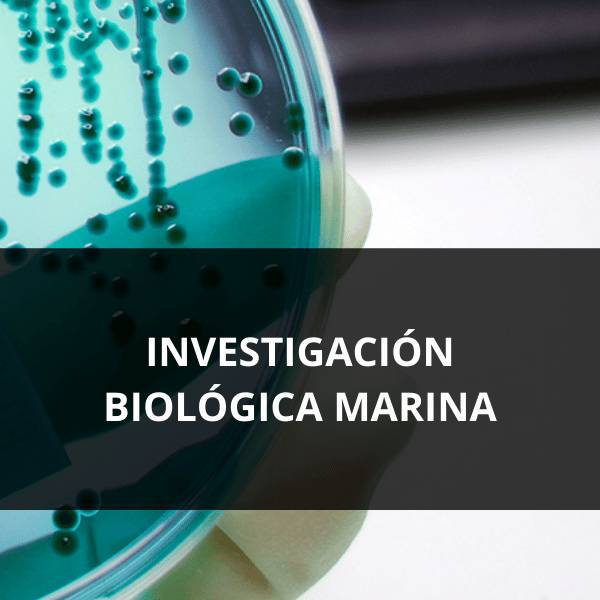

LipoTrue se especializa en la obtención de ingredientes activos avanzados a través de innovadoras plataformas tecnológicas: plantas silvestres utilizadas como biofactorías, tecnologías In Silico y diseño biomimético de péptidos, bioinvestigación marina, LipoTrue Greenbeat™ y análisis de datos masivos.
Cada una de estas plataformas tecnológicas cuenta con un equipo de investigación y desarrollo especializado que trabaja de manera coordinada para ofrecer una cartera sólida de productos con ingredientes activos de alta eficacia y originalidad.


TECNOLOGÍA
LipoTrue se especializa en desarrollar ingredientes activos avanzados utilizando tecnologías de vanguardia, tales como el uso de plantas silvestres como biofactorías, el diseño biomimético de péptidos a través de In Silico, la investigación marina, LipoTrue Greenbeat™ y el análisis de datos masivos.
Cada una de estas plataformas tecnológicas tiene su propio equipo de investigación y desarrollo, que trabajan en conjunto para ofrecer una gama robusta de productos con ingredientes activos innovadores y altamente efectivos.

Nuevos productos disponibles
PRODUCTOS SOBRE PEDIDO

Meiview™, un producto de Mallorca, España, mejora el contorno de los ojos al fortalecer la piel, aumentar el colágeno y mejorar la circulación. Reduce bolsas y ojeras en ambos sexos, inspirado en los beneficios revitalizantes del Mediterráneo.


Joybliss™ rejuvenece la piel, mejora las arrugas y la luminosidad, alivia el eritema y promueve un estado de ánimo positivo, reduciendo el estrés para una piel más joven y una sensación de felicidad total.

iPeptide™ combate los efectos del insomnio y el estrés en la piel, reduce la inflamación, fortalece las defensas y mejora la apariencia de la piel. Actúa como la melatonina, protegiendo la piel y mejorando las ojeras y párpados caídos.

Anargy™ utiliza tecnología de plantas para producir proteínas veganas que fortalecen el cabello y las pestañas, mejorando su crecimiento, densidad y apariencia.

Æonome™ es un agebiótico de una cueva en Mallorca que mejora la salud de la piel, protege contra el envejecimiento y mejora la apariencia de la piel.

Årctalis™ es un ingrediente marino que mejora y protege la piel, aportando alisado, firmeza, hidratación y luminosidad.

Calisensix™, obtenido de la corteza del sauce blanco y células madre del tomate, alivia la inflamación y las molestias de la piel sensible, mejorando la autopercepción. Actúa como un coach de mindfulness para tu piel.








